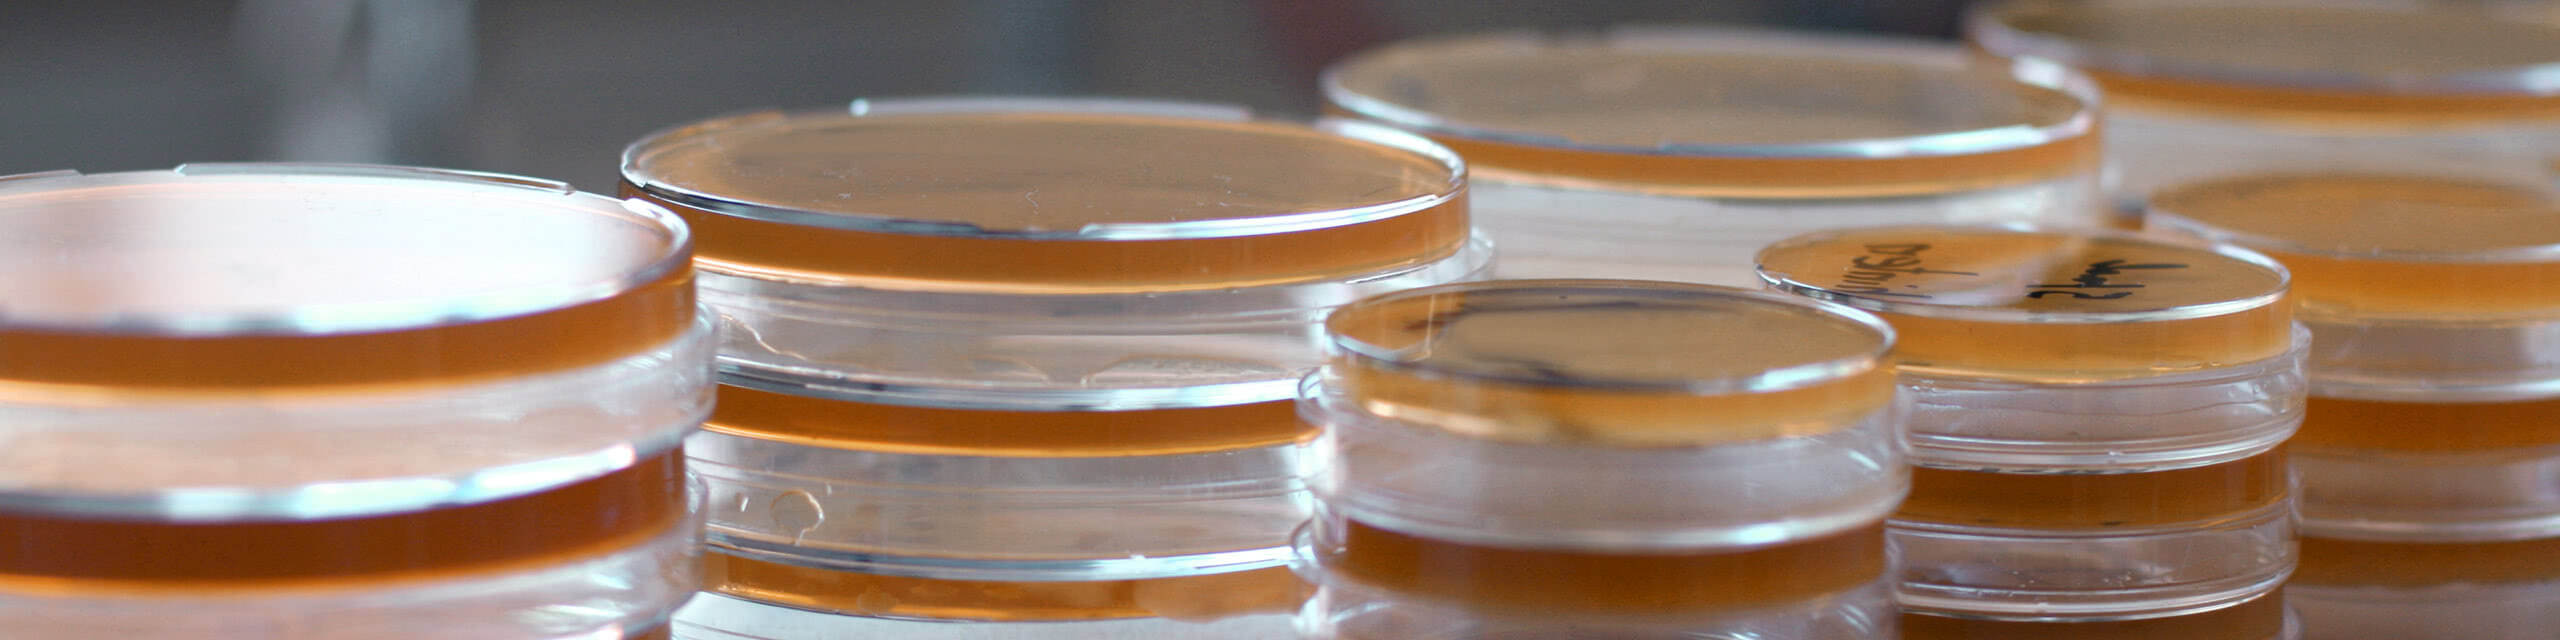

Zentrale Aufgabe eines Fruchtsaft-Sommeliers ist, Qualitätsbewusstsein sowie Wissen über die Vielfalt und Wertigkeit von Frucht- und Gemüsesäften zu vermitteln. Um durch sach- und fachkundige Multiplikatoren die Kommunikation mit dem Konsumenten zu stärken und die Lust auf Saftgenuss zu vermitteln, bieten die Doemens Akademie und das confructa colleg eine weltweit einzigartige Ausbildung an: Seit 2019 werden Interessierte im Rahmen eines drei-moduligen Lehrgangs zum Experten in Sachen Fruchtsaft, Gemüsesaft und Smoothies ausgebildet.

Doemens ist bekannt für seine Schankanlagenexpertise und ist in Deutschland autorisierter Lehrgangsträger sowie seit November 2019 Prüfungslaboratorium für Getränkeschankanlagen. Umfangreiche Kenntnisse über die Technik und Hygiene einer Getränkeschankanlage sowie deren Gefährdungsbeurteilung sind in der heutigen Zeit wichtiger denn je und müssen aus Sicht der zuständigen Überwachungsbehörden nachgewiesen werden. Bei der Vermittlung dieser Kenntnisse ist Doemens genau der richtige Ansprechpartner. Neben der fachlichen Qualität mit hohem Praxisbezug kommt den Seminarteilnehmern zugute, dass sich die theoretisch vermittelten Inhalte am Doemens-Schankanlagenzentrum transparent darstellen lassen.


Der Biermarkt ist nicht einfach, die Anforderungen des Verbrauchers noch weniger. Was macht eine Brauerei zukunftsfähig, welche Produkte treffen den Geschmack der nächsten Generation? Und wie lassen sich Qualität, Technologie und Konsumentenerwartung vereinen? Die Doemens Impulse 2026 drehen sich um Erfolgsfaktoren von morgen – für Brauereien, die neue Wege gehen und mit Innovation und Sensorik überzeugen wollen. In Impulsvorträgen, Praxisbeispielen und Diskussionen spannen wir den Bogen von Trends im Verbraucherverhalten über technologische Entwicklungen bis hin zu neuen Perspektiven auf Drinkability, alkoholfreie Spezialitäten und Biermischgetränke. Frische Ideen, spannende Impulse mit konkreten Lösungen für die Brauerei von morgen und klasse Networking-Möglichkeiten.

Ziel der Ausbildung zum Genuss-Sommelier alkoholfrei ist es, umfassendes Wissen und praktische Fähigkeiten in der Kreation hochwertiger und innovativer alkoholfreier Getränke zu vermitteln. Diese reichen von (Mineral)-Wasser, Fruchtsaft, Tee und Kaffee über Fermentationsgetränke wie Kombucha, Shrubs und Kefir bis hin zu individuellen Signature-Drinks.
